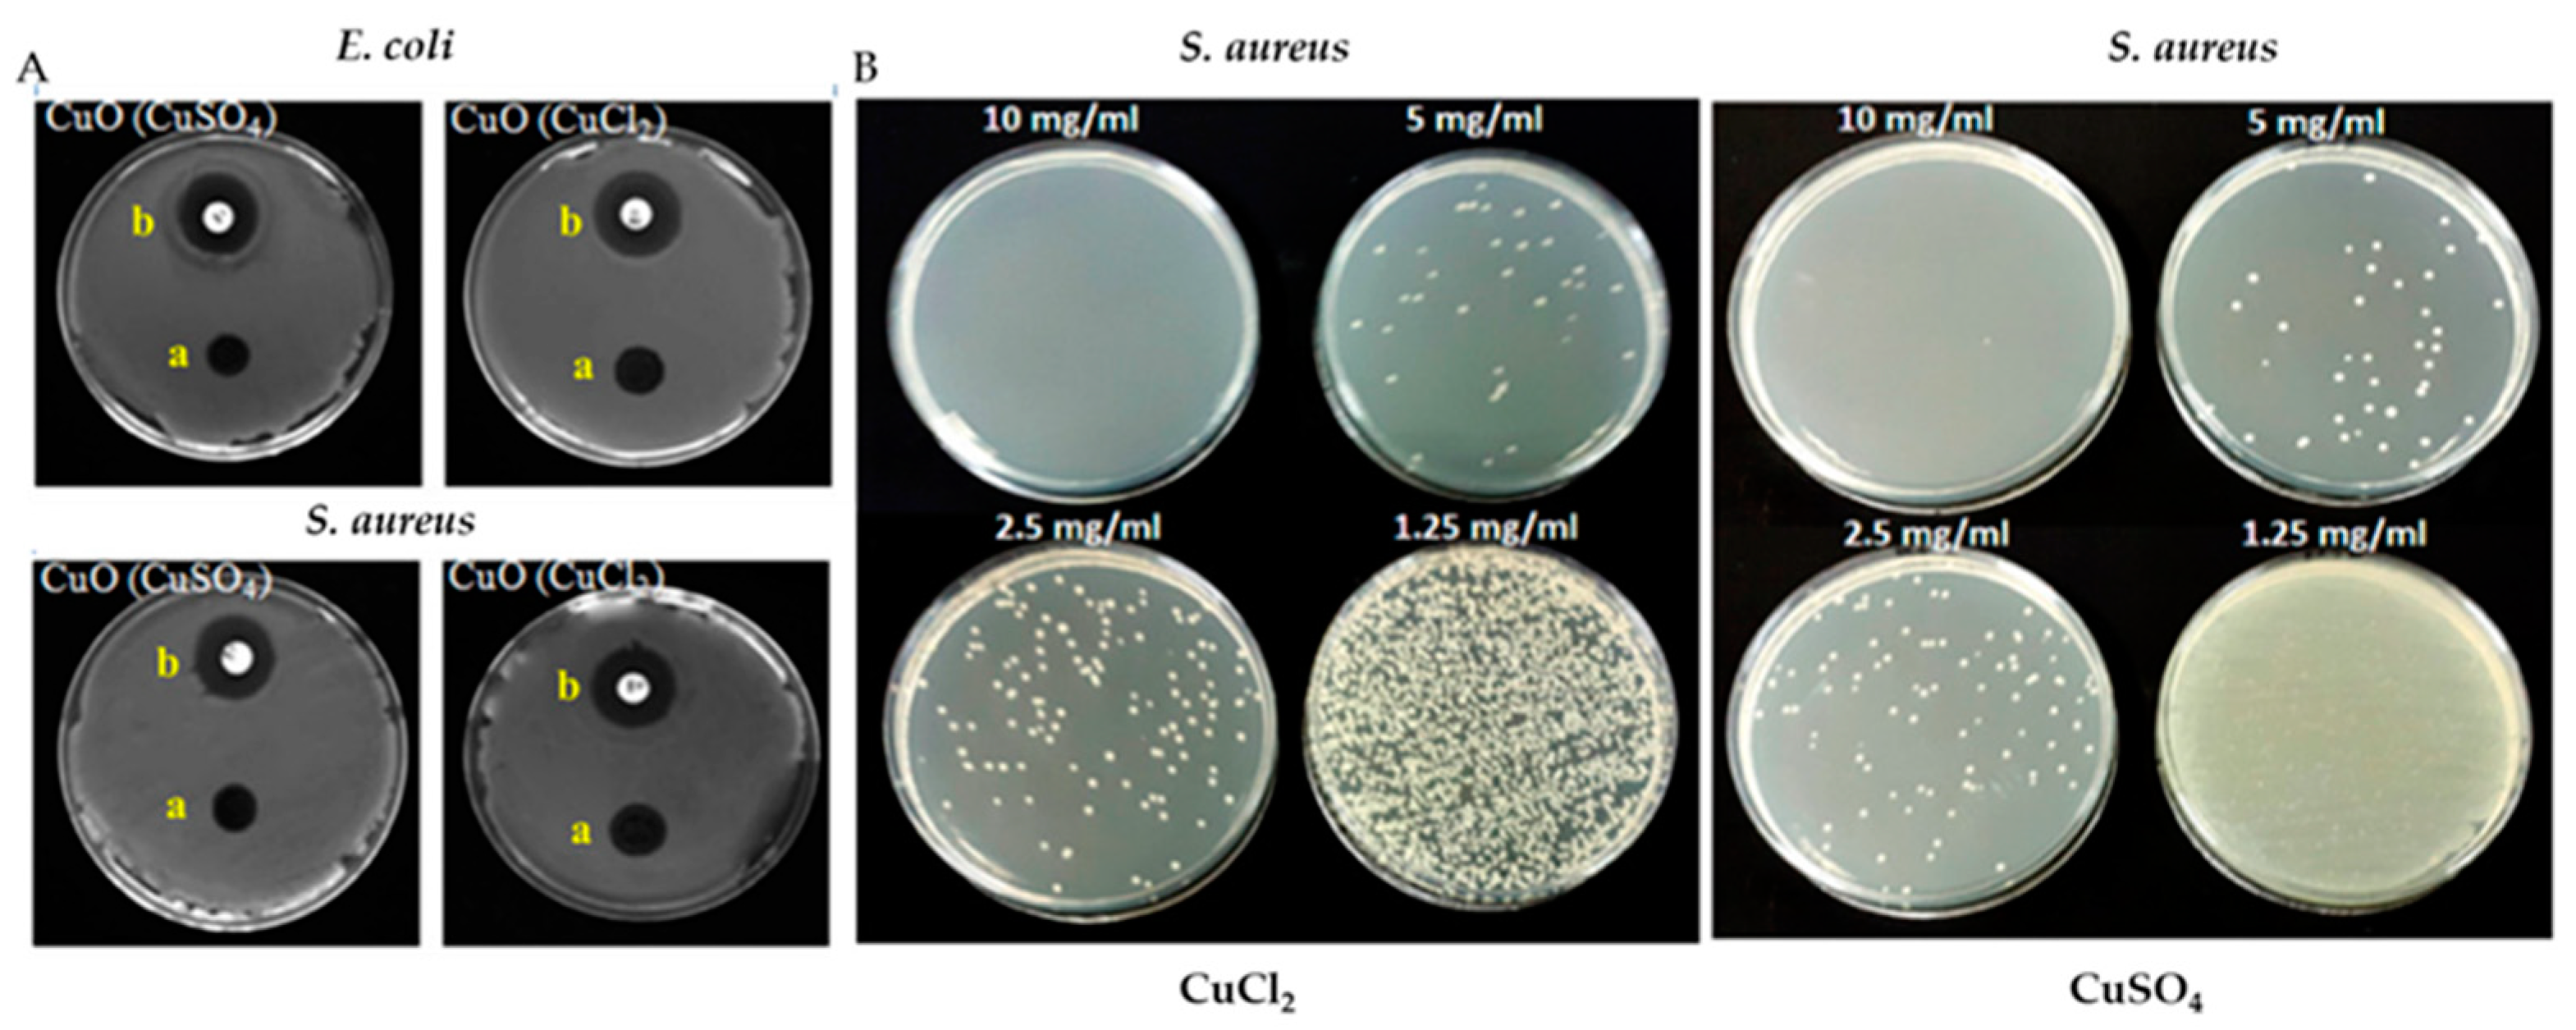
Materials 16 01460 g007

Mechanochemical Synthesis of Nanoparticles for Potential Antimicrobial Applications
Abstract
1. Introduction
2. Main Strategies for Synthesis of Nanoparticles
3. Mechanochemistry: History and Advantages
- (i)
- Reduction of particle size: ball milling is a physical method that affords the synthesis of particles with reduced sizes down to tens of nanometers.
- (ii)
- Nanostructuring and activation of materials: mechanical grinding can be used for the synthesis of mesoporous materials via template-assisted methods. In addition, mechanochemistry can be applied for the nano-casting synthesis of nanoporous materials [63].
- (iii)
- Doping of nanoparticles: the activity of nanomaterials mainly depends on their surface-to-volume ratio, size, and surface functionality, as well as the active sites present on the surface. The surface properties of NPs can be modified by doping, which is commonly used to enhance their catalytic activity, antimicrobial properties, etc. Moreover, doping permits the realization of desired properties for specific applications such as wastewater treatment, nuclear waste management, and adsorption-based removal of harmful dyes [64,65,66].
- (iv)
- Reduction of reaction time: mechanochemical processing is quicker than conventional synthesis. The reduction of tungsten carbide particles from 2–3 mm sizes to 3 µm takes 70 h in conventional synthesis, whereas the same can be achieved in 3 min in a planetary ball mill [67].
- (v)
- (vi)
- Low agglomeration: this approach helps to produce the NPs with narrow particle size distribution [70].
- (vii)
- Medicinal value: the use of modern mechanochemistry in the medicinal field as medicinal mechanochemistry expands the scope of this approach [71].
4. Mechanochemical Synthesis of Nanoparticles
- SPEX shaker mills
- Planetary ball mills
- Attritor mills
- Modern mills (rod mills, vibrating frame mills)
4.1. Synthesis of Metal Nanoparticles
4.2. Synthesis of Metal Oxide Nanoparticles
4.3. Synthesis of Nanoalloys and Nanocomposites
4.4. Use of Mechanochemistry for Doping and Incorporating Various Species
4.5. Mechanochemical Synthesis of Highly Porous Nanoparticles
5. Antimicrobial Applications of Mechanochemically-Synthesized Nanoparticles
5.1. Antimicrobial Properties of Nanoparticles
5.2. Porous Materials as Antimicrobial Agents
5.3. Role of Nanoparticles in Antimicrobial Resistance or Multi-Drug Resistance
- (i)
- Direct exposure to the bacterial cell causing the cell membrane damage;
- (ii)
- Biofilm inhibition;
- (iii)
- Generation of reactive oxygen species (ROS); and
- (iv)
- Disruption of transcription and translation processes.
6. Conclusions and Perspectives
Funding
Institutional Review Board Statement
Informed Consent Statement
Data Availability Statement
Acknowledgments
Conflicts of Interest
References
- Lancaster, C.A.; Scholl, W.E.; Ticknor, M.A.; Shumaker-Parry, J.S. Uniting top-down and bottom-up strategies using fabricated nanostructures as hosts for synthesis of nanomites. J. Phys. Chem. C 2020, 124, 6822–6829. [Google Scholar] [CrossRef]
- Chandra, S.; Kumar, A.; Tomar, P.K. Synthesis of Al nanoparticles: Transmission electron microscopy, thermal and spectral studies. Spectrochim. Acta A Mol. Biomol. Spectrosc. 2012, 92, 392–397. [Google Scholar] [CrossRef] [PubMed]
- Guisbiers, G.; Mejía Rosales, S.; Deepak, F.L. Nanomaterial properties: Size and shape dependencies. J. Nanomater. 2012, 2012, 180976. [Google Scholar] [CrossRef]
- Chauruka, S.R.; Hassanpour, A.; Brydson, R.; Roberts, K.J.; Ghadiri, M.; Stitt, H. Effect of mill type on the size reduction and phase transformation of gamma alumina. Chem. Eng. Sci. 2015, 134, 774–783. [Google Scholar] [CrossRef]
- Li, J.; Wu, Q.; Wu, J. Synthesis of nanoparticles via solvothermal and hydrothermal methods. In Handbook of Nanoparticles; Springer: Berlin/Heidelberg, Germany, 2016; pp. 295–328. [Google Scholar] [CrossRef]
- Gedanken, A. Using sonochemistry for the fabrication of nanomaterials. Ultrason Sonochem 2004, 11, 47–55. [Google Scholar] [CrossRef]
- Luo, X.L.; Pei, F.; Wang, W.; Qian, H.M.; Miao, K.K.; Pan, Z.; Chen, Y.S.; Feng, G.D. Microwave synthesis of hierarchical porous materials with various structures by controllable desilication and recrystallization. Microporous Mesoporous Mater. 2018, 262, 148–153. [Google Scholar] [CrossRef]
- Szczęśniak, B.; Borysiuk, S.; Choma, J.; Jaroniec, M. Mechanochemical synthesis of highly porous materials. Mater. Horiz. 2020, 7, 1457–1473. [Google Scholar] [CrossRef]
- Ramyadevi, J.; Jeyasubramanian, K.; Marikani, A.; Rajakumar, G.; Rahuman, A.A. Synthesis and antimicrobial activity of copper nanoparticles. Mater. Lett. 2012, 71, 114–116. [Google Scholar] [CrossRef]
- Stankic, S.; Suman, S.; Haque, F.; Vidic, J. Pure and multi metal oxide nanoparticles: Synthesis, antibacterial and cytotoxic properties. J. Nanobiotechnology. 2016, 14, 73. [Google Scholar] [CrossRef]
- Da Silva, B.L.; Abuçafy, M.P.; Manaia, E.B.; Junior, J.A.O.; Chiari-Andréo, B.G.; Pietro, R.C.R.; Chiavacci, L.A. Relationship between structure and antimicrobial activity of zinc oxide nanoparticles: An overview. Int. J. Nanomed. 2019, 14, 9395–9410. [Google Scholar] [CrossRef]
- Menazea, A.A.; Ahmed, M.K. Wound healing activity of chitosan/polyvinyl alcohol embedded by gold nanoparticles prepared by nanosecond laser ablation. J. Mol. Struct. 2020, 1217, 128401–128409. [Google Scholar] [CrossRef]
- Seyedi, M.; Haratian, S.; Khaki, J.V. Mechanochemical synthesis of Fe2O3 nanoparticles. Procedia Mater. Sci. 2015, 11, 309–313. [Google Scholar] [CrossRef]
- Amrute, A.P.; De Bellis, J.; Felderhoff, M.; Schüth, F. Mechanochemical synthesis of catalytic materials. Chem.–A Eur. J. 2021, 27, 6819–6847. [Google Scholar] [CrossRef] [PubMed]
- Xu, C.; De, S.; Balu, A.M.; Ojeda, M.; Luque, R. Mechanochemical synthesis of advanced nanomaterials for catalytic applications. Chem. comm. 2015, 51, 6698–6713. [Google Scholar] [CrossRef] [PubMed]
- Takacs, L. Self-sustaining reactions induced by ball milling. Prog. Mater. Sci. 2002, 47, 355–414. [Google Scholar] [CrossRef]
- Paskevicius, M.; Webb, J.; Pitt, M.P.; Blach, T.P.; Hauback, B.C.; Gray, E.M.; Buckley, C.E. Mechanochemical synthesis of aluminium nanoparticles and their deuterium sorption properties to 2 kbar. J. Alloys Compd. 2009, 481, 595–599. [Google Scholar] [CrossRef]
- Kalimuthu, K.; Cha, B.S.; Kim, S.; Park, K.S. Eco-friendly synthesis and biomedical applications of gold nanoparticles: A review. Microchem. J. 2020, 152, 104296. [Google Scholar] [CrossRef]
- Pica, A.; Guran, C.; Ficai, D.; Ficai, A.; Dumitru, F. Acrylic polymer influence on the structure and morphology of AgNPs obtained by chemical method for antimicrobial applications. J. Coat. Technol. Res. 2016, 13, 53–61. [Google Scholar] [CrossRef]
- Guzmán, M.G.; Dille, J.; Godet, S. Synthesis of silver nanoparticles by chemical reduction method and their antibacterial activity. Int. J. Chem. Biomol. Eng. 2009, 2, 104–111. [Google Scholar]
- Karthik, A.D.; Geetha, K. Synthesis of copper precursor, copper and its oxide nanoparticles by green chemical reduction method and its antimicrobial activity. J. Appl. Pharm. Sci. 2011, 3, 016–021. [Google Scholar] [CrossRef]
- Khan, A.; Rashid, A.; Younas, R.; Chong, R. A chemical reduction approach to the synthesis of copper nanoparticles. Int. Nano Lett. 2016, 6, 21–26. [Google Scholar] [CrossRef]
- Liu, M.S.; Lin, M.C.C.; Tsai, C.Y.; Wang, C.C. Enhancement of thermal conductivity with Cu for nanofluids using chemical reduction method. Int. J. Heat Mass Transf. 2006, 49, 3028–3033. [Google Scholar] [CrossRef]
- Deraedt, C.; Salmon, L.; Gatard, S.; Ciganda, R.; Hernandez, R.; Ruiz, J.; Astruc, D. Sodium borohydride stabilizes very active gold nanoparticle catalysts. Chem. Comm. 2014, 50, 14194–14196. [Google Scholar] [CrossRef] [PubMed]
- Khanna, P.K.; Singh, N.; Charan, S.; Subbarao, V.V.V.S.; Gokhale, R.; Mulik, U.P. Synthesis and characterization of Ag/PVA nanocomposite by chemical reduction method. Mater. Chem. Phys. 2005, 93, 117–121. [Google Scholar] [CrossRef]
- Lin, C.Y.; Mohanty, U.S.; Chou, J.H. High temperature synthesis of Sn–3.5 Ag–0.5 Zn alloy nanoparticles by chemical reduction method. J. Alloys Compd. 2010, 501, 204–210. [Google Scholar] [CrossRef]
- McCormick, P.G.; Froes, F.H. The fundamentals of mechanochemical processing. J. Osteopath. Med. 1998, 50, 61–65. [Google Scholar] [CrossRef]
- Khan, M.; Shaik, M.R.; Khan, S.T.; Adil, S.F.; Kuniyil, M.; Khan, M.; Al-Warthan, A.A.; Siddiqui, M.R.H.; Nawaz Tahir, M. Enhanced antimicrobial activity of biofunctionalized zirconia nanoparticles. ACS Omega 2020, 5, 1987–1996. [Google Scholar] [CrossRef]
- Hossain, O.; Rahman, E.; Roy, H.; Azam, M.S.; Ahmed, S. Synthesis, characterization, and comparative assessment of antimicrobial properties and cytotoxicity of graphene-, silver-, and zinc-based nanomaterials. Anal. Sci. Adv. 2022, 3, 54–63. [Google Scholar] [CrossRef]
- Mahdy, N.K.; El-Sayed, M.; Al-Mofty, S.E.D.; Mohamed, A.; Karaly, A.H.; El-Naggar, M.E.; Nageh, H.; Sarhan, W.A.; El-Said Azzazy, H.M. Toward scaling up the production of metal oxide nanoparticles for application on washable antimicrobial cotton fabrics. ACS Omega 2022, 7, 38942–38956. [Google Scholar] [CrossRef]
- Khezerlou, A.; Alizadeh-Sani, M.; Azizi-Lalabadi, M.; Ehsani, A. Nanoparticles and their antimicrobial properties against pathogens including bacteria, fungi, parasites, and viruses. Microb. Pathog. 2018, 123, 505–526. [Google Scholar] [CrossRef]
- Wang, L.; Hu, C.; Shao, L. The antimicrobial activity of nanoparticles: Present situation and prospects for the future. Int. J. Nanomed. 2017, 12, 1227–1249. [Google Scholar] [CrossRef]
- Correa, M.G.; Martínez, F.B.; Vidal, C.P.; Streitt, C.; Escrig, J.; de Dicastillo, C.L. Antimicrobial metal-based nanoparticles: A review on their synthesis, types, and antimicrobial action. Beilstein J. Nanotechnol. 2020, 11, 1450–1469. [Google Scholar] [CrossRef] [PubMed]
- Tsuzuki, T. Mechanochemical synthesis of metal oxide nanoparticles. Commun. Chem. 2021, 4, 143. [Google Scholar] [CrossRef] [PubMed]
- Rak, M.J.; Friščić, T.; Moores, A. Mechanochemical synthesis of Au, Pd, Ru and Re nanoparticles with lignin as a bio-based reducing agent and stabilizing matrix. Faraday Discuss. 2014, 170, 155–167. [Google Scholar] [CrossRef]
- Nguyen, T.A.; Mai, T.Y.; Nguyen, T.X.M.; Huynh, K.P.H.; Le, M.V.; Nguyen, T. Mechanochemical synthesis of zinc oxide nanoparticles and their antibacterial activity against escherichia coli. Mater. Sci. Forum 2020, 1007, 59–64. [Google Scholar] [CrossRef]
- Kharissova, O.V.; Kharisov, B.I.; Oliva González, C.M.; Méndez, Y.P.; López, I. Greener synthesis of chemical compounds and materials. R. Soc. Open Sci. 2019, 6, 191378–191419. [Google Scholar] [CrossRef] [PubMed]
- Zaman, S.B.; Hussain, M.A.; Nye, R.; Mehta, V.; Mamun, K.T.; Hossain, N. A review on antibiotic resistance: Alarm bells are ringing. Cureus 2017, 9, e1403. [Google Scholar] [CrossRef] [PubMed]
- Saga, T.; Yamaguchi, K. History of antimicrobial agents and resistant bacteria. Japan Med. Assoc. J. 2009, 52, 103–108. [Google Scholar]
- Boucher, H.W.; Talbot, G.H.; Bradley, J.S.; Edwards, J.E.; Gilbert, D.; Rice, L.B.; Scheld, M.; Spellberg, B.; Bartlett, J. Bad bugs, no drugs: No ESKAPE! An update from the Infectious Diseases Society of America. Clin. Infect. Dis. 2009, 48, 1–12. [Google Scholar] [CrossRef]
- Livermore, D.M. Discovery research: The scientific challenge of finding new antibiotics. J. Antimicrob. Chemother. 2011, 66, 1941–1944. [Google Scholar] [CrossRef]
- Ribeiro da Cunha, B.; Fonseca, L.P.; Calado, C.R. Antibiotic discovery: Where have we come from, where do we go? Antibiotics 2019, 8, 45. [Google Scholar] [CrossRef] [PubMed]
- Herrmann, M.; Nkuiya, B.; Dussault, A.R. Innovation and antibiotic use within antibiotic classes: Market incentives and economic instruments. Resour. Energy Econ. 2013, 35, 582–598. [Google Scholar] [CrossRef]
- Dehghanghadikolaei, A.; Ansary, J.; Ghoreishi, R. Sol-gel process applications: A mini-review. Proc. Nat. Res. Soc. 2018, 2, 02008–02029. [Google Scholar] [CrossRef]
- Hayle, S.T.; Gonfa, G.G. Synthesis and characterization of titanium oxide nanomaterials using sol-gel method. Am. J. Nanosci. Nanotechnol. 2014, 2, 1. [Google Scholar] [CrossRef]
- Ye, N.; Yan, T.; Jiang, Z.; Wu, W.; Fang, T. A review: Conventional and supercritical hydro/solvothermal synthesis of ultrafine particles as cathode in lithium battery. Ceram. Int. 2018, 44, 4521–4537. [Google Scholar] [CrossRef]
- Ghimire, P.P.; Jaroniec, M. Renaissance of Stöber method for synthesis of colloidal particles: New developments and opportunities. J. Colloid Interface Sci. 2021, 584, 838–865. [Google Scholar] [CrossRef]
- Liu, Y.; Xiao, M.; Liu, S.; Zhao, X.; Tian, Y.; Wang, X. A novel oil-water microemulsion strategy for controllable synthesis of large mesoporous carbon nanoparticles. Carbon 2022, 200, 361–374. [Google Scholar] [CrossRef]
- Becerra-Paniagua, D.K.; Díaz-Cruz, E.B.; Baray-Calderón, A.; Garcia-Angelmo, A.R.; Regalado-Pérez, E.; del Pilar Rodriguez-Torres, M.; Martínez-Alonso, C. Nanostructured metal sulfides synthesized by microwave-assisted heating: A review. J. Mater. Sci. Mater. Electron. 2022, 33, 22631–22667. [Google Scholar] [CrossRef]
- Hassanin, H.A.; Taha, A. Sonochemical-assisted biogenic synthesis of theophrasite β-Ni (OH)2 nanocluster using chia seeds extract: Characterization and anticancer activity. Nanomaterials 2022, 12, 1919. [Google Scholar] [CrossRef]
- Mackenzie, J.D.; Bescher, E.P. Chemical routes in the synthesis of nanomaterials using the sol–gel process. Acc. Chem. Res. 2007, 40, 810–818. [Google Scholar] [CrossRef]
- Stöber, W.; Fink, A.; Bohn, E. Controlled growth of monodisperse silica spheres in the micron size range. J. Colloid Interface Sci. 1968, 26, 62–69. [Google Scholar] [CrossRef]
- Rajapantulu, A.; Bandyopadhyaya, R. Formation of gold nanoparticles in water-in-oil microemulsions: Experiment, mechanism, and simulation. Langmuir 2021, 37, 6623–6631. [Google Scholar] [CrossRef] [PubMed]
- Tadic, M.; Trpkov, D.; Kopanja, L.; Vojnovic, S.; Panjan, M. Hydrothermal synthesis of hematite (α-Fe2O3) nanoparticle forms: Synthesis conditions, structure, particle shape analysis, cytotoxicity, and magnetic properties. J. Alloys Compd. 2019, 792, 599–609. [Google Scholar] [CrossRef]
- Liu, Z.L.; Wang, X.; Yao, K.L.; Du, G.H.; Lu, Q.H.; Ding, Z.H.; Tao, J.; Ning, Q.; Luo, X.P.; Tian, D.Y.; et al. Synthesis of magnetite nanoparticles in W/O microemulsion. J. Mater. Sci. 2004, 39, 2633–2636. [Google Scholar] [CrossRef]
- Lu, T.; Wang, J.; Yin, J.; Wang, A.; Wang, X.; Zhang, T. Surfactant effects on the microstructures of Fe3O4 nanoparticles synthesized by microemulsion method. Colloids Surf. A Physicochem. Eng. Asp. 2013, 436, 675–683. [Google Scholar] [CrossRef]
- Salabat, A.; Mirhoseini, F. A novel and simple microemulsion method for synthesis of biocompatible functionalized gold nanoparticles. J. Mol. Liq. 2018, 268, 849–853. [Google Scholar] [CrossRef]
- Solanki, J.N.; Sengupta, R.; Murthy, Z.V.P. Synthesis of copper sulphide and copper nanoparticles with microemulsion method. Solid State Sci. 2010, 12, 1560–1566. [Google Scholar] [CrossRef]
- Yıldırım, Ö.A.; Durucan, C. Synthesis of zinc oxide nanoparticles elaborated by microemulsion method. J. Alloys Compd. 2010, 506, 944–949. [Google Scholar] [CrossRef]
- Xu, H.; Zeiger, B.W.; Suslick, K.S. Sonochemical synthesis of nanomaterials. Chem. Soc. Rev. 2013, 42, 2555–2567. [Google Scholar] [CrossRef]
- Głowniak, S.; Szczęśniak, B.; Choma, J.; Jaroniec, M. Advances in microwave synthesis of nanoporous materials. Adv. Mater. 2021, 33, 2103477–2103505. [Google Scholar] [CrossRef]
- McNaught, A.D. Compendium of chemical terminology. Oxf. Blackwell Sci. 1997, 1669, 1–464. [Google Scholar]
- Xiao, W.; Yang, S.; Zhang, P.; Li, P.; Wu, P.; Li, M.; Chen, N.; Jie, K.; Huang, C.; Zhang, N.; et al. Facile synthesis of highly porous metal oxides by mechanochemical nanocasting. Chem. Mater. 2018, 30, 2924–2929. [Google Scholar] [CrossRef]
- Bulina, N.V.; Vinokurova, O.B.; Eremina, N.V.; Prosanov, I.Y.; Khusnutdinov, V.R.; Chaikina, M.V. Features of solid phase mechanochemical synthesis of hydroxyapatite doped by copper and zinc ions. J. Solid State Chem. 2021, 296, 121973–121980. [Google Scholar] [CrossRef]
- Subramonian, W.; Wu, T.Y.; Chai, S.P. Using one-step facile and solvent-free mechanochemical process to synthesize photoactive Fe2O3-TiO2 for treating industrial wastewater. J. Alloys Compd. 2017, 695, 496–507. [Google Scholar] [CrossRef]
- Ulbrich, K.F.; Nishida, E.N.; Souza, B.S.; Campos, C.E.M. NiS2-NiS nanocrystalline composite synthesized by mechanochemistry and its performance for methylene blue dye adsorption. Mater. Chem. Phys. 2020, 252, 123226–123235. [Google Scholar] [CrossRef]
- Wieczorek-Ciurowa, K.; Gamrat, K. Some aspects of mechanochemical reactions. Mater. Sci.-Pol. 2007, 25, 219–232. [Google Scholar]
- He, X.; Deng, Y.; Zhang, Y.; He, Q.; Xiao, D.; Peng, M.; Zhao, Y.; Zhang, H.; Luo, R.; Gan, T.; et al. Mechanochemical kilogram-scale synthesis of noble metal single-atom catalysts. Cell Rep. Phys. Sci. 2020, 1, 100004–100017. [Google Scholar] [CrossRef]
- Zhang, L.; Shi, H.; Tan, X.; Jiang, Z.; Wang, P.; Qin, J. Ten-gram-scale mechanochemical synthesis of ternary lanthanum coordination polymers for antibacterial and antitumor activities. Front. Chem. 2022, 10, 898324. [Google Scholar] [CrossRef]
- Stanković, A.; Veselinović, L.J.; Škapin, S.D.; Marković, S.; Uskoković, D. Controlled mechanochemically assisted synthesis of ZnO nanopowders in the presence of oxalic acid. J. Mater. Sci. 2011, 46, 3716–3724. [Google Scholar] [CrossRef]
- Tan, D.; Loots, L.; Friščić, T. Towards medicinal mechanochemistry: Evolution of milling from pharmaceutical solid form screening to the synthesis of active pharmaceutical ingredients (APIs). Chem. Comm. 2016, 52, 7760–7781. [Google Scholar] [CrossRef]
- Chin, P.P.; Ding, J.; Yi, J.B.; Liu, B.H. Synthesis of FeS2 and FeS nanoparticles by high-energy mechanical milling and mechanochemical processing. J. Alloys Compd. 2005, 390, 255–260. [Google Scholar] [CrossRef]
- Jamkhande, P.G.; Ghule, N.W.; Bamer, A.H.; Kalaskar, M.G. Metal nanoparticles synthesis: An overview on methods of preparation, advantages and disadvantages, and applications. J. Drug Deliv. Sci. Technol. 2019, 53, 101174–101185. [Google Scholar] [CrossRef]
- de Oliveira, P.F.; Torresi, R.M.; Emmerling, F.; Camargo, P.H. Challenges, and opportunities in the bottom-up mechanochemical synthesis of noble metal nanoparticles. J. Mater. Chem. A 2020, 8, 16114–16141. [Google Scholar] [CrossRef]
- Suryanarayana, C. Mechanical alloying, and milling. Prog. Mater. Sci. 2001, 46, 1–184. [Google Scholar] [CrossRef]
- Baláž, M.; Daeu, N.; Balážová, Ľ.; Dutková, E.; Tkáčiková, Ľ.; Briančin, J.; Vargová, M.; Balážová, M.; Zorkovská, A.; Baláž, P. Bio-mechanochemical synthesis of silver nanoparticles with antibacterial activity. Adv. Powder Technol. 2017, 28, 3307–3312. [Google Scholar] [CrossRef]
- Tsuzuki, T.; McCormick, P.G. Mechanochemical synthesis of nanoparticles. J. Mater. Sci. 2004, 39, 5143–5146. [Google Scholar] [CrossRef]
- Baláž, M.; Tešinský, M.; Marquardt, J.; Škrobian, M.; Daneu, N.; Rajňák, M.; Baláž, P. Synthesis of copper nanoparticles from refractory sulfides using a semi-industrial mechanochemical approach. Adv. Powder Technol. 2000, 31, 782–791. [Google Scholar] [CrossRef]
- Baláž, M.; Zorkovská, A.; Urakaev, F.; Baláž, P.; Briančin, J.; Bujňáková, Z.; Achimovičová, M.; Gock, E. Ultrafast mechanochemical synthesis of copper sulfides. R. Soc. Chem. Adv. 2016, 6, 87836–87842. [Google Scholar] [CrossRef]
- Khayati, G.R.; Janghorban, K. The nanostructure evolution of Ag powder synthesized by high energy ball milling. Adv. Powder Technol. 2012, 23, 393–397. [Google Scholar] [CrossRef]
- Tsuzuki, T.; Pirault, E.; McCormick, P.G. Mechanochemical synthesis of gadolinium oxide nanoparticles. Nanostructured Mater. 1999, 11, 125–131. [Google Scholar] [CrossRef]
- Tsuzuki, T.; McCormick, P.G. Synthesis of Cr2O3 nanoparticles by mechanochemical processing. Acta Mater. 2000, 48, 2795–2801. [Google Scholar] [CrossRef]
- Ao, W.; Li, J.; Yang, H.; Zeng, X.; Ma, X. Mechanochemical synthesis of zinc oxide nanocrystalline. Powder Technol. 2006, 168, 148–151. [Google Scholar] [CrossRef]
- Aghababazadeh, R.; Mazinani, B.; Mirhabibi, A.; Tamizifar, M. ZnO nanoparticles synthesized by mechanochemical processing. J. Phys. Conf. Ser. 2006, 26, 312–314. [Google Scholar] [CrossRef]
- Dodd, A.C.; McCormick, P.G. Synthesis of nanocrystalline ZrO2 powders by mechanochemical reaction of ZrCl4 with LiOH. J. Eur. Ceram. Soc. 2002, 22, 1823–1829. [Google Scholar] [CrossRef]
- Li, Y.X.; Zhou, X.Z.; Wang, Y.; You, X.Z. Preparation of nano sized CeO2 by mechanochemical reaction of cerium carbonate with sodium hydroxide. Mater. Lett. 2004, 58, 245–249. [Google Scholar] [CrossRef]
- Yang, H.; Hu, Y.; Tang, A.; Jin, S.; Qiu, G. Synthesis of tin oxide nanoparticles by mechanochemical reaction. J. Alloys Compd. 2004, 363, 276–279. [Google Scholar] [CrossRef]
- Yang, H.; Qiu, G.; Zhang, X.; Tang, A.; Yang, W. Preparation of CdO nanoparticles by mechanochemical reaction. J. Nanopart. Res. 2004, 6, 539–542. [Google Scholar] [CrossRef]
- Yang, H.; Hu, Y.; Zhang, X.; Qiu, G. Mechanochemical synthesis of cobalt oxide nanoparticles. Mater. Lett. 2004, 58, 387–389. [Google Scholar] [CrossRef]
- Dodd, A.; McKinley, A.; Tsuzuki, T.; Saunders, M. Optical and photocatalytic propertie of nanocrystalline TiO2 synthesized by solid-state chemical reaction. J. Phys. Chem. Solids 2007, 68, 2341–2348. [Google Scholar] [CrossRef]
- Wei, X.; Wang, X.; Gao, B.; Zou, W.; Dong, L. Facile ball-milling synthesis of CuO/biochar nanocomposites for efficient removal of reactive red 120. ACS Omega 2020, 5, 5748–5755. [Google Scholar] [CrossRef]
- Li, Z.; Wang, Y.; Yu, Q. Significant parameters in the optimization of synthesis of silver nanoparticles by chemical reduction method. J. Mater. Eng. Perform. 2010, 19, 252–256. [Google Scholar] [CrossRef]
- Baláž, M.; Goga, M.; Hegdüs, M.; Daneu, N.; Kováčová, M.; Tkáčiková, L.U.; Balážová, L.U.; Bačkor, M. Biomechanochemical solid-state synthesis of silver nanoparticles with antibacterial activity using lichens. ACS Sustain. Chem. Eng. 2020, 8, 13945–13955. [Google Scholar] [CrossRef]
- Itoh, H.; Naka, K.; Chujo, Y. Synthesis of gold nanoparticles modified with ionic liquid based on the imidazolium cation. J. Am. Chem. Soc. 2004, 126, 3026–3027. [Google Scholar] [CrossRef] [PubMed]
- Mallik, M.; Monia, S.; Gupta, M.; Ghosh, A.; Toppo, M.P.; Roy, H. Synthesis, and characterization of Cu2O nanoparticles. J. Alloys Compd. 2020, 829, 154623–154629. [Google Scholar] [CrossRef]
- Khayati, G.R.; Nourafkan, E.; Karimi, G.; Moradgholi, J. Synthesis of cuprous oxide nanoparticles by mechanochemical oxidation of copper in high planetary energy ball mill. Adv. Powder Technol. 2013, 24, 301–305. [Google Scholar] [CrossRef]
- Wang, W.W.; Zhu, Y.J.; Ruan, M.L. Microwave-assisted synthesis and magnetic property of magnetite and hematite nanoparticles. J. Nanopart. Res. 2007, 9, 419–426. [Google Scholar] [CrossRef]
- Talebian, N.; Amininezhad, S.M.; Doudi, M. Controllable synthesis of ZnO nanoparticles and their morphology-dependent antibacterial and optical properties. J. Photochem. Photobiol. B Biol. 2013, 120, 66–73. [Google Scholar] [CrossRef]
- Manzoor, U.; Siddique, S.; Ahmed, R.; Noreen, Z.; Bokhari, H.; Ahmad, I. Antibacterial, structural, and optical characterization of mechano-chemically prepared ZnO nanoparticles. PLoS ONE 2016, 11, 0154704–0154716. [Google Scholar] [CrossRef]
- De Bellis, J.; Felderhoff, M.; Schüth, F. Mechanochemical synthesis of supported bimetallic catalysts. Chem. Mater. 2021, 33, 2037–2045. [Google Scholar] [CrossRef]
- Chaudhary, V.; Zhong, Y.; Parmar, H.; Sharma, V.; Tan, X.; Ramanujan, R.V. Mechanochemical synthesis of iron and cobalt magnetic metal nanoparticles and iron/calcium oxide and cobalt/calcium oxide nanocomposites. Chem. Open 2018, 7, 590–598. [Google Scholar] [CrossRef]
- Shah, P.M.; Day, A.N.; Davies, T.E.; Morgan, D.J.; Taylor, S.H. Mechanochemical preparation of ceria-zirconia catalysts for the total oxidation of propane and naphthalene volatile organic compounds. Appl. Catal. B Environ. 2019, 253, 331–340. [Google Scholar] [CrossRef]
- Aysin, B.; Ozturk, A.; Park, J. Silver-loaded TiO2 powders prepared through mechanical ball milling. Ceram. Int. 2013, 39, 7119–7126. [Google Scholar] [CrossRef]
- Casco, M.E.; Kirchhoff, S.; Leistenschneider, D.; Rauche, M.; Brunner, E.; Borchardt, L. Mechanochemical synthesis of N-doped porous carbon at room temperature. Nanoscale 2019, 11, 4712–4718. [Google Scholar] [CrossRef] [PubMed]
- Abu Bakar, S.A.S.; Ramesh, S.; Sopyan, I.; Tan, C.Y.; Hamdi, M.; Teng, W.D. Mechanochemical synthesis of magnesium doped hydroxyapatite: Powder characterization. Appl. Mech. Mater. 2013, 372, 62–65. [Google Scholar] [CrossRef]
- He, R.; Hocking, R.K.; Tsuzuki, T. Local structure, and photocatalytic property of mechanochemical synthesized ZnO doped with transition metal oxides. J. Aust. Ceram. Soc. 2013, 49, 70–75. Available online: http://hdl.handle.net/10536/DRO/DU:30057625 (accessed on 31 December 2012).
- Thommes, M.; Kaneko, K.; Neimark, A.V.; Olivier, J.P.; Rodriguez-Reinoso, F.; Rouquerol, J.; Sing, K.S. Physisorption of gases, with special reference to the evaluation of surface area and pore size distribution (IUPAC Technical Report). Pure Appl. Chem. 2015, 87, 1051–1069. [Google Scholar] [CrossRef]
- Du, S.; Wu, Y.; Wang, X.; Xia, Q.; Xiao, J.; Zhou, X.; Li, Z. Facile synthesis of ultramicroporous carbon adsorbents with ultra-high CH4 uptake by in situ ionic activation. AIChE J. 2020, 66, 16231–16240. [Google Scholar] [CrossRef]
- Zhang, P.; Wang, L.; Yang, S.; Schott, J.A.; Liu, X.; Mahurin, S.M.; Huang, C.; Zhang, Y.; Fulvio, P.F.; Chisholm, M.F.; et al. Solid-state synthesis of ordered mesoporous carbon catalysts via a mechanochemical assembly through coordination cross-linking. Nat.Commun. 2017, 8, 15020. [Google Scholar] [CrossRef]
- Szczęśniak, B.; Choma, J.; Jaroniec, M. Facile mechanochemical synthesis of highly mesoporous γ-Al2O3 using boehmite. Microporous Mesoporous Mater. 2021, 312, 110792–110799. [Google Scholar] [CrossRef]
- Weidner, E.; Dubadi, R.; Samojeden, B.; Piasecki, A.; Jesionowski, T.; Jaroniec, M.; Ciesielczyk, F. Mechanochemical synthesis of alumina-based catalysts enriched with vanadia and lanthana for selective catalytic reduction of nitrogen oxides. Sci. Rep. 2022, 12, 21294. [Google Scholar] [CrossRef]
- Zhao, B.; Zheng, Y.; Ye, F.; Deng, X.; Xu, X.; Liu, M.; Shao, Z. Multifunctional iron oxide nanoflake/graphene composites derived from mechanochemical synthesis for enhanced lithium storage and electrocatalysis. ACS Appl. Mater. Interfaces. 2015, 7, 14446–14455. [Google Scholar] [CrossRef] [PubMed]
- Klimakow, M.; Klobes, P.; Thünemann, A.F.; Rademann, K.; Emmerling, F. Mechanochemical synthesis of metal− organic frameworks: A fast and facile approach toward quantitative yields and high specific surface areas. Chem. Mater. 2010, 22, 5216–5221. [Google Scholar] [CrossRef]
- Tang, S.L.; Smith, R.L.; Poliakoff, M. Principles of green chemistry: Productively. Green Chem. 2005, 7, 761–762. [Google Scholar] [CrossRef]
- Dushkin, A.V.; Gol’dina, I.A.; Gus’kov, S.A.; Evseenko, V.I.; Lyakhov, N.Z.; Kozlov, V.A. Antimicrobial activity of mechanochemically synthesized composites of antibiotics and nanostructured silicon dioxide. Dokl. Biochem. Biophys. 2012, 443, 61–63. [Google Scholar] [CrossRef]
- Petronella, F.; De Biase, D.; Zaccagnini, F.; Verrina, V.; Lim, S.I.; Jeong, K.U.; Miglietta, S.; Petrozza, V.; Scognamiglio, V.; Godman, N.P.; et al. Label-free and reusable antibody-functionalized gold nanorod arrays for the rapid detection of Escherichia coli cells in a water dispersion. Environ. Sci. Nano 2022, 9, 3343–3360. [Google Scholar]
- Yin, I.X.; Zhang, J.; Zhao, I.S.; Mei, M.L.; Li, Q.; Chu, C.H. The antibacterial mechanism of silver nanoparticles and its application in dentistry. Int. J. Nanomed. 2020, 15, 2555–2562. Available online: https://www.tandfonline.com/doi/abs/10.2147/IJN.S246764 (accessed on 5 January 2023). [CrossRef]
- Hochvaldová, L.; Večeřová, R.; Kolář, M.; Prucek, R.; Kvítek, L.; Lapčík, L.; Panáček, A. Antibacterial nanomaterials: Upcoming hope to overcome antibiotic resistance crisis. Nanotechnol. Rev. 2022, 11, 1115–1142. [Google Scholar] [CrossRef]
- Lemire, J.A.; Harrison, J.J.; Turner, R.J. Antimicrobial activity of metals: Mechanisms, molecular targets, and applications. Nat. Rev. Microbiol. 2013, 11, 371–384. [Google Scholar] [CrossRef]
- Durán, N.; Durán, M.; De Jesus, M.B.; Seabra, A.B.; Fávaro, W.J.; Nakazato, G. Silver nanoparticles: A new view on mechanistic aspects on antimicrobial activity. Nanomed. Nanotechnol. Biol. Med. 2016, 12, 789–799. [Google Scholar] [CrossRef]
- Javadhesari, S.M.; Alipour, S.; Mohammadnejad, S.; Akbarpour, M.R. Antibacterial activity of ultra-small copper oxide (II) nanoparticles synthesized by mechanochemical processing against S. aureus and E. coli. Mater. Sci. Eng. C 2019, 105, 110011–110021. [Google Scholar] [CrossRef]
- Sarkar, S.; Chatterjee, R.; Mukherjee, A.; Mukherjee, D.; Chandra Mandal, N.; Mahato, S.; Santra, S.; Zyryanov, G.V.; Majee, A. Mechanochemical synthesis and antimicrobial studies of 4-hydroxy-3-thiomethylcoumarins using imidazolium zwitterionic molten salt as an organocatalyst. ACS Sust. Chem. Eng. 2021, 9, 5557–5569. [Google Scholar] [CrossRef]
- Al-Bogami, A.S. Mechanochemical synthesis of cyclohexenones and indazoles as potential antimicrobial agents. Res. Chem. Intermed. 2016, 42, 5457–5477. [Google Scholar] [CrossRef]
- Baláž, M.; Bedlovičová, Z.; Daneu, N.; Siksa, P.; Sokoli, L.; Tkáčiková, Ľ.; Salayová, A.; Džunda, R.; Kováčová, M.; Bureš, R.; et al. Mechanochemistry as an alternative method of green synthesis of silver nanoparticles with antibacterial activity: A comparative study. Nanomaterials 2021, 11, 1139. [Google Scholar] [CrossRef] [PubMed]
- Manogar, P.; Morvinyabesh, J.E.; Ramesh, P.; Jeyaleela, G.D.; Amalan, V.; Ajarem, J.S.; Allam, A.A.; Khim, J.S.; Vijayakumar, N. Biosynthesis and antimicrobial activity of aluminium oxide nanoparticles using Lyngbya majuscula extract. Mater. Lett. 2022, 311, 131569–131573. [Google Scholar] [CrossRef]
- Dassanayake, T.M.; Dassanayake, A.C.; Abeydeera, N.; Pant, B.D.; Jaroniec, M.; Kim, M.H.; Huang, S.D. An aluminum lining to the dark cloud of silver resistance: Harnessing the power of potent antimicrobial activity of γ-alumina nanoparticles. Biomater. Sci. 2021, 9, 7996–8006. [Google Scholar] [CrossRef]
- Urnukhsaikhan, E.; Bold, B.E.; Gunbileg, A.; Sukhbaatar, N.; Mishig-Ochir, T. Antibacterial activity and characteristics of silver nanoparticles biosynthesized from Carduus crispus. Sci. Rep. 2021, 11, 21047. [Google Scholar] [CrossRef]
- Sathiyaraj, S.; Suriyakala, G.; Gandhi, A.D.; Babujanarthanam, R.; Almaary, K.S.; Chen, T.W.; Kaviyarasu, K. Biosynthesis, characterization, and antibacterial activity of gold nanoparticles. J. Infect. Public Health 2021, 14, 1842–1847. [Google Scholar] [CrossRef]
- Bogdanović, U.; Lazić, V.; Vodnik, V.; Budimir, M.; Marković, Z.; Dimitrijević, S. Copper nanoparticles with high antimicrobial activity. Mater. Lett. 2014, 128, 75–78. [Google Scholar] [CrossRef]
- Pallela, P.N.V.K.; Ummey, S.; Ruddaraju, L.K.; Gadi, S.; Cherukuri, C.S.; Barla, S.; Pammi, S.V.N. Antibacterial efficacy of green synthesized α-Fe2O3 nanoparticles using Sida cordifolia plant extract. Heliyon 2019, 5, 02765–02772. [Google Scholar] [CrossRef]
- Arakha, M.; Pal, S.; Samantarrai, D.; Panigrahi, T.K.; Mallick, B.C.; Pramanik, K.; Mallick, B.; Jha, S. Antimicrobial activity of iron oxide nanoparticle upon modulation of nanoparticle-bacteria interface. Sci. Rep. 2015, 5, 14813. [Google Scholar] [CrossRef]
- Nawaz, M.; Tahir, M.B.; Iqbal, T.; Pervaiz, M.; Rafique, M.; Aziz, F.; Younas, U.; Alrobei, H. Synthesis, characterization, and antibacterial activity of NiO NPs against pathogen. Inorg. Chem. Commun. 2020, 122, 108300–108307. [Google Scholar] [CrossRef]
- Janaki, A.C.; Sailatha, E.; Gunasekaran, S. Synthesis, characteristics, and antimicrobial activity of ZnO nanoparticles. Spectrochim. Acta A Mol. Biomol. Spectrosc. 2015, 144, 17–22. [Google Scholar] [CrossRef] [PubMed]
- Liu, G.; Li, S.; Lu, Y.; Zhang, J.; Feng, Z.; Li, C. Controllable synthesis of α-Bi2O3 and γ-Bi2O3 with high photocatalytic activity by α-Bi2O3→ γ-Bi2O3→ α-Bi2O3 transformation in a facile precipitation method. J. Alloys Compd. 2016, 689, 787–799. [Google Scholar] [CrossRef]
- Gopalan, S.; Singhal, S.C. Mechanochemical synthesis of nano sized CeO2. Scr. Mater. 2000, 42, 993–996. [Google Scholar] [CrossRef]
- Abbas, A.K.; Abass, S.K.; Bashi, A.M. CuO nano particles synthesized via the mechanichanical method starting with solids state chemichal reactions. IOP Conf. Ser. Mater. Sci. Eng. 2019, 571, 012067–012078. [Google Scholar] [CrossRef]
- Tang, A.; Li, X.; Zhou, Z.; Ouyang, J.; Yang, H. Mechanochemical synthesis of Ni (OH)2 and the decomposition to NiO nanoparticles: Thermodynamic and optical spectra. J. Alloys Compd. 2014, 600, 204–209. [Google Scholar] [CrossRef]
- Billik, P.; Čaplovičová, M. Synthesis of nanocrystalline SnO2 powder from SnCl4 by mechanochemical processing. Powder Technol. 2009, 191, 235–239. [Google Scholar] [CrossRef]
- Billik, P.; Plesch, G. Mechanochemical synthesis of nanocrystalline TiO2 from liquid TiCl4. Scr. Mater. 2007, 56, 979–982. [Google Scholar] [CrossRef]
- Otis, G.; Ejgenberg, M.; Mastai, Y. Solvent-free mechanochemical synthesis of ZnO nanoparticles by high-energy ball milling of ε-Zn (OH) 2 crystals. Nanomaterials 2021, 11, 238. [Google Scholar] [CrossRef]
- Ding, J.; Tsuzuki, T.; McCormick, P.G. Mechanochemical synthesis of ultrafine ZrO2 powder. Nanostructured Mater. 1997, 8, 75–81. [Google Scholar] [CrossRef]
- Jibril, S.; Sani, S.; Kurawa, M.A.; Shehu, S.M. Mechanochemical synthesis, characterization, and antimicrobial screening of Metal (II) complexes derived from amoxicillin. Bayero J. Pure Appl. Sci. 2019, 12, 106–111. [Google Scholar] [CrossRef]
- Cao, X.L.; Zhang, Q.H.; Pan, X.H.; Chen, Z.; Lü, J. Mechanochemical synthesis of nano–ciprofloxacin with enhanced antibacterial activity. Inorg. Chem. Commun. 2019, 102, 66–69. [Google Scholar] [CrossRef]
- Arancon, R.A.; Balu, A.M.; Romero, A.A.; Ojeda, M.; Gomez, M.; Blanco, J.; Domingo, J.L.; Luque, R. Mechanochemically synthesized Ag-based nanohybrids with unprecedented low toxicity in biomedical applications. Environ. Res. 2017, 154, 204–211. [Google Scholar] [CrossRef] [PubMed]
- Shalabayev, Z.; Baláz, M.; Daneu, N.; Dutková, E.; Bujnáková, Z.; Kanuchová, M.; Danková, Z.; Balázová, L.; Urakaev, F.; Tkáciková, L.; et al. Sulfur-mediated mechanochemical synthesis of spherical and needle-like copper sulfide nanocrystals with antibacterial activity. ACS Sustain. Chem. Eng. 2019, 7, 12897–12909. [Google Scholar] [CrossRef]
- Baláž, M.; Augustyniak, A.; Tatykayev, B.; Shalabayev, Z.; Burashev, G.; Dutková, E.; Daneu, N.; Briančin, J.; Balážová, Ľ.; Tkáčiková, Ľ.; et al. Mechanochemical synthesis of non-stoichiometric copper sulfide Cu 1.8 S applicable as a photocatalyst and antibacterial agent and synthesis scalability verification. Faraday Discuss. 2023, 241, 367–386. [Google Scholar] [CrossRef]
- Rak, M.J.; Friščić, T.; Moores, A. One-step, solvent-free mechanosynthesis of silver nanoparticle-infused lignin composites for use as highly active multidrug resistant antibacterial filters. RSC Adv. 2016, 6, 58365–58370. [Google Scholar] [CrossRef]
- Kováčová, M.; Daneu, N.; Tkáčiková, Ľ.; Búreš, R.; Dutková, E.; Stahorský, M.; Bujňáková, Z.L.; Baláž, M. Sustainable one-step solid-state synthesis of antibacterially active silver nanoparticles using mechanochemistry. Nanomaterials 2020, 10, 2119. [Google Scholar] [CrossRef]
- Karageorgou, D.; Thomou, E.; Vourvou, N.T.; Lyra, K.M.; Chalmpes, N.; Enotiadis, A.; Spyrou, K.; Katapodis, P.; Gournis, D.; Stamatis, H. Antibacterial and algicidal effects of porous carbon cuboid nanoparticles. ACS Omega 2019, 4, 4991–5001. [Google Scholar] [CrossRef]
- Lin, Y.S.; Hurley, K.R.; Haynes, C.L. Critical considerations in the biomedical use of mesoporous silica nanoparticles. J. Phys. Chem. Lett. 2012, 3, 364–374. [Google Scholar] [CrossRef]
- Darpentigny, C.; Marcoux, P.R.; Menneteau, M.; Michel, B.; Ricoul, F.; Jean, B.; Bras, J.; Nonglaton, G. Antimicrobial cellulose nanofibril porous materials obtained by supercritical impregnation of thymol. ACS Appl. Bio Mater. 2020, 3, 2965–2975. [Google Scholar] [CrossRef]
- Mohammed, H.; Kumar, A.; Bekyarova, E.; Al-Hadeethi, Y.; Zhang, X.; Chen, M.; Ansari, M.S.; Cochis, A.; Rimondini, L. Antimicrobial mechanisms and effectiveness of graphene and graphene-functionalized biomaterials. A scope reviews. Front. Bioeng. Biotechnol. 2020, 8, 465–487. [Google Scholar] [CrossRef] [PubMed]
- Lyon, D.Y.; Brunet, L.; Hinkal, G.W.; Wiesner, M.R.; Alvarez, P.J. Antibacterial activity of fullerene water suspensions (nC60) is not due to ROS-mediated damage. Nano Lett. 2008, 8, 1539–1543. [Google Scholar] [CrossRef] [PubMed]
- Brunet, L.; Lyon, D.Y.; Hotze, E.M.; Alvarez, P.J.; Wiesner, M.R. Comparative photoactivity and antibacterial properties of C60 fullerenes and titanium dioxide nanoparticles. Env. Sci. Technol. 2009, 43, 4355–4360. [Google Scholar] [CrossRef] [PubMed]
- Gupta, A.; Saleh, N.M.; Das, R.; Landis, R.F.; Bigdeli, A.; Motamedchaboki, K.; Campos, A.R.; Pomeroy, K.; Mahmoudi, M.; Rotello, V.M. Synergistic antimicrobial therapy using nanoparticles and antibiotics for the treatment of multidrug-resistant bacterial infection. Nano Futures 2017, 1, 015004–0154015. [Google Scholar] [CrossRef]
- Lee, N.Y.; Ko, W.C.; Hsueh, P.R. Nanoparticles in the treatment of infections caused by multidrug-resistant organisms. Front. Pharmacol. 2019, 10, 1153–1163. [Google Scholar] [CrossRef]
- Pelgrift, R.Y.; Friedman, A.J. Nanotechnology as a therapeutic tool to combat microbial resistance. Adv. Drug Deliv. Rev. 2013, 65, 1803–1815. [Google Scholar] [CrossRef]

| Solvent-Based Synthesis | Mechanochemical Synthesis | ||||
|---|---|---|---|---|---|
| Samples (NPs) | Size (nm) | Hazardous Chemicals Used | Refs. | Size (nm) | Ref. |
| Ag | 8–50 | Hydrazine hydrate, Sodium hypophosphite | [10,92] | 39–100 | [93] |
| Au | 22 ± 4.6 | NaBH4 | [94] | 14.8 ± 6.8 | [36] |
| Cu2O | 7.5 ± 1.8 | NaBH4, NaOH | [95] | 11 | [96] |
| Fe2O3 | 50 | H2O2, N2H4 | [97] | 4.21 | [13] |
| ZnO | 45–76 | Ammonia | [98] | <20 ± 5 | [99] |
| Sample (NPs) | Synthesis | Size (nm) | Microorganism | ZOI, MIC | Refs. |
|---|---|---|---|---|---|
| Al2O3 | Plant Extract, Ultrasonication | 96.10, 11–15 | E. coli, S. aureus, P. aeruginosa | 2.5–10 µg/mL | [125,126] |
| Ag | Biosynthesis | - | Proteus, E. coli, Bacillus, Pseudomonas | 6–15 mm | [127] |
| Au | Biosynthesis | 53.3 | B. subtilis, E. coli, K. pneumoniae. | 11.42–17.12 mm | [128] |
| Cu | Bio reduction | 5.3 | E. coli, C. albicans. | Microbial reduction (84–99%) | [129] |
| Fe2O3 | Biosynthesis | - | B. subtilis, S. aureus, E. coli, K. pneumoniae | 10–16 mm | [130] |
| Fe3O4 | Co-Precipitation | E. coli, B. Subtilis | 6.25 µg/mL | [131] | |
| NiO | Plant Extract | 2–21 | E. coli, S. aureus | 12 µg/mL 10 µg/mL | [132] |
| ZnO | Plant Extract | 24.5 | K. pneumoniae, S. aureus | 9 mm | [133] |
| Sample (NPs) | Reaction Involved | Milling Time | Size (nm) | Refs. |
|---|---|---|---|---|
| Bi2O3 | α Bi2O3 + (ZnO, Fe2O3, SiO2) ⟶ metal oxides doped γ Bi2O3 | 5 min–10 h | 22.5–67 | [134] |
| CeO2 | CeCl3 + 1.5 CaO + 0.25 O2 ⟶ CeO2 + 1.5 CaCl2 | 24 | 19 | [135] |
| Cr2O3 | Na2Cr2O7 +S ⟶ Cr2O3 + Na2SO4 | - | 10–80 | [82] |
| CuO | CuSO4·5H2O + C6H5(COOH)(OH) + 3NaOH ⟶ CuO +Na2SO4 + C6H5(COONa)(OH) + H2 + 7H2O | 30 min | 11.59–22.09 | [136] |
| Fe2O3 | FeCl3·6H2 + Na2CO ⟶ Fe2O3·6H2O + 6NaCl + 3CO2 | 2–5 h | 4 | [98] |
| Gd2O3 | GdCl3 + 3NaOH + 11 NaCl ⟶ Gd (OH)2 + 4NaCl | 24 | 20 | [81] |
| NiO | NiCl2·6H2O + NaOH ⟶ Ni (OH)2 + NaCl | 30 min | 8–80 | [137] |
| SnO2 | SnCl4 + (NH4)2CO3 ⟶ SnO2·H2O + NH4Cl + 3CO2 | 5 min | 3–48 | [138] |
| TiO2 | TiCl4+ (NH4)2CO3 ⟶ TiO2·H2O + 4NH4Cl | 5 min | 10–50 | [139] |
| ZnO | εZn (OH)2 ⟶ ZnO + H2O ZnCl2 +Na2CO3 + 6NaCl ⟶ ZnCO3 + 8NaCl Zn (CH3COO)2 + NaOH ⟶ 2CH3COONa + Zn (OH)2 | 30 min–6 h | 9–36 | [36,140] |
| ZrO2 | ZrCl4 + 2CaO ⟶ ZrO2 + 2CaCl2 | 20 | 8 | [141] |
Disclaimer/Publisher’s Note: The statements, opinions and data contained in all publications are solely those of the individual author(s) and contributor(s) and not of MDPI and/or the editor(s). MDPI and/or the editor(s) disclaim responsibility for any injury to people or property resulting from any ideas, methods, instructions or products referred to in the content. |
© 2023 by the authors. Licensee MDPI, Basel, Switzerland. This article is an open access article distributed under the terms and conditions of the Creative Commons Attribution (CC BY) license (https://creativecommons.org/licenses/by/4.0/).
Share and Cite
Dubadi, R.; Huang, S.D.; Jaroniec, M. Mechanochemical Synthesis of Nanoparticles for Potential Antimicrobial Applications. Materials 2023, 16, 1460. https://doi.org/10.3390/ma16041460
Dubadi R, Huang SD, Jaroniec M. Mechanochemical Synthesis of Nanoparticles for Potential Antimicrobial Applications. Materials. 2023; 16(4):1460. https://doi.org/10.3390/ma16041460
Chicago/Turabian StyleDubadi, Rabindra, Songping D. Huang, and Mietek Jaroniec. 2023. "Mechanochemical Synthesis of Nanoparticles for Potential Antimicrobial Applications" Materials 16, no. 4: 1460. https://doi.org/10.3390/ma16041460
APA StyleDubadi, R., Huang, S. D., & Jaroniec, M. (2023). Mechanochemical Synthesis of Nanoparticles for Potential Antimicrobial Applications. Materials, 16(4), 1460. https://doi.org/10.3390/ma16041460

